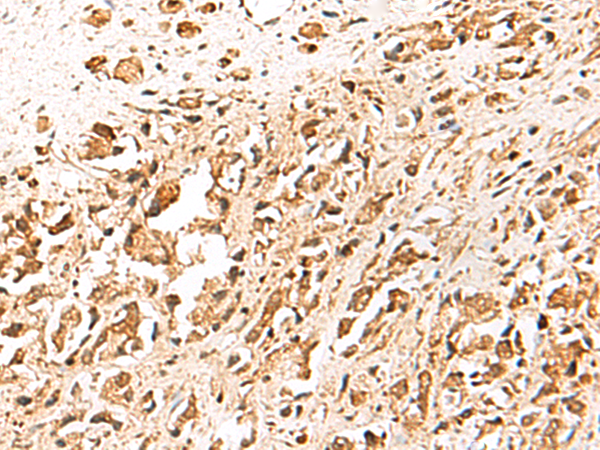
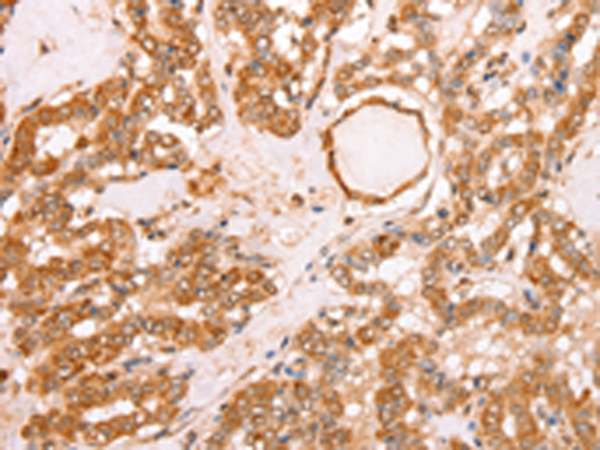
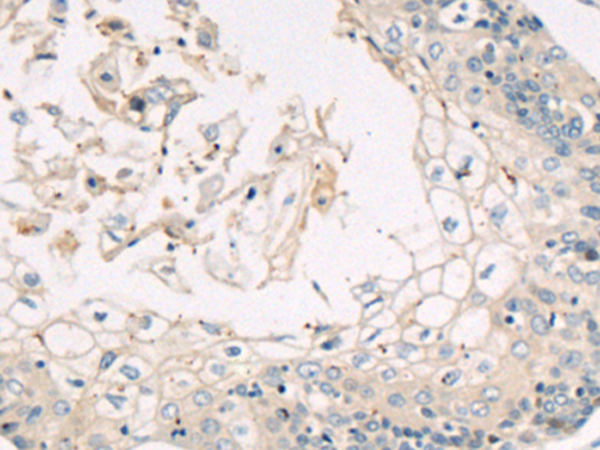

-
分类: 科研抗体货号: P07686别名: HT2A; BBS11; TATIP; LGMD2H应用: WB,IHC反应种属: Human, Mouse
-
分类: 科研抗体货号: P07685别名: P23; TEBP; cPGES应用: IHC反应种属: Human, Mouse, Rat
-
分类: 科研抗体货号: P07705别名: XBP2; TREB5; XBP-1应用: IHC反应种属: Human
-
分类: 科研抗体货号: P07684别名: TRF; PIN2; TRF1; TRBF1; t-TRF1; hTRF1-AS应用: WB,IHC反应种属: Human, Mouse
-
分类: 科研抗体货号: P07703别名: VF; PBEF; PBEF1; VISFATIN; 1110035O14Rik应用: WB,IHC反应种属: Human, Mouse, Rat
-
分类: 科研抗体货号: P07683别名: TL2; APO2L; CD253; TRAIL; Apo-2L; TNLG6A应用: IHC反应种属: Human
-
分类: 科研抗体货号: P07701别名: PEP3应用: WB,IHC反应种属: Human
-
分类: 科研抗体货号: P07681别名: T6BP; TXBP151; CALCOCO3应用: IHC反应种属: Human, Mouse, Rat
-
分类: 科研抗体货号: P07700别名: UGB; UP1; CC10; CC16; CCSP; UP-1; CCPBP应用: IHC反应种属: Human
-
分类: 科研抗体货号: P07680别名: RNF85; MGC:3310应用: WB,IHC反应种属: Human, Mouse, Rat

鄂公网安备42018502007531号
鄂公网安备42018502007531号

